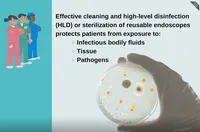
Jessica Alicdan

Making Heads or Tails of Uncertainties and Inconsistencies in Endoscope Reprocessing
Speaker sessionJeri Culbertson, J. Alicdan, Tamara Behm
AORN - Global Surgical Conference
New Orleans, Louisiana • April 13 2026 @ 8-9am


Jeri Culbertson, J. Alicdan, Tamara Behm
AORN - Global Surgical Conference
New Orleans, Louisiana • April 13 2026 @ 8-9am

Jessica Alicdan
APIC 26
Nashville, Tennessee • June 15 2026 @ 2:15-3:15pm

Myers, F., Delahanty, K., Virgalito, M., Alicdan, J., Jopp, D.
San Diego & Imperial County APIC Annual Conference
Pala Mesa Resort, Fallbrook, California, United States • October 2025

Alicdan, J.
Infectious Disease Association of California (IDAC) 38th Annual Southern California Symposium
Hyatt Regency Huntington Beach, Huntington Beach, California, United States • July 2024

Alicdan, J.
APIC 2024 Annual Conference & Exposition
San Antonio, Texas, United States • June 2024

Feldheim, A., Alicdan J., Fong. C., Myers. F., Torriani. F.
Association for Vascular Access (AVA) 2023 Annual Scientific Meeting
Portland, OR, United States • October 14-17, 2023

Feldheim, A., Alicdan J., Fong. C., Myers. F., Torriani. F.
APIC 2023 Annual Conference & Exposition
Orlando FL, United States • June 26-28, 2023

Esteban, J., Banister, S., Alicdan, J.
AAACN 48th Annual Conference
Orlando, FL, United States • April 11-15, 2023
Horton, L., Abeles, S., Alicdan, J., Patel, P., Keehner, J., Kremer, B., Ikeda, L., Ikeda, T., Torriani., F., Taplitz, R.
IDWeek 2020 Virtual Conference
United States • October 21-25, 2020

Alicdan, J.
UCLA's 17th Annual Research and Evidence Based Practice Conference
Los Angeles, CA, United States • September 28, 2018

Alicdan, J., Johnston., H., Bamberg, W.
Public Health in the Rockies Conference
Vail, CO, United States • September 16-18, 2015

Alicdan, J., Amador, L., Bakhiet, N., Atwater., J., Wahlund., T.
Advance Technical Education Conference
Washington D.C., United States
